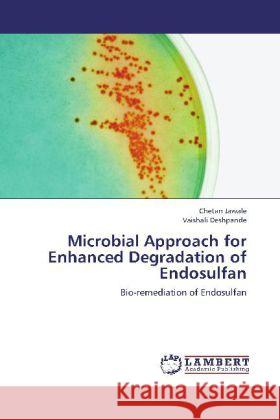
Microbial Approach for Enhanced Degradation of Endosulfan : Bio-remediation of Endosulfan Jawale, Chetan; Deshpande, Vaishali 9783659257469 LAP Lambert Academic Publishing - książka

Microbial Approach for Enhanced Degradation of Endosulfan : Bio-remediation of Endosulfan » książka
Microbial Approach for Enhanced Degradation of Endosulfan : Bio-remediation of Endosulfan
ISBN-13: 9783659257469 / Angielski / Miękka / 2012 / 140 str.
Microbial Approach for Enhanced Degradation of Endosulfan : Bio-remediation of Endosulfan
ISBN-13: 9783659257469 / Angielski / Miękka / 2012 / 140 str.
(netto: 251,93 VAT: 5%)
Najniższa cena z 30 dni: 264,53
ok. 10-14 dni roboczych
Bez gwarancji dostawy przed świętami
Darmowa dostawa!
Over the last decades, awareness of pesticide hazards increasing worldwide. Endosulfan is banned in most of the countries; though its effectiveness against the crop pest and availability continued its use extensively among the farmers of developing countries. Traditional, legal enforcement and public campaigns is no longer adequate to prevent the use of such pesticides in agriculture field. This book therefore provides a new insight of bioremediation of such hazardous pesticide using isolated microorganisms from such heavily polluted areas. Five separate chapters present information of present scenario of endosulfan, detail methodology and protocols for the isolation and culture of endosulfan degrading bacterial strains. Detail qualitative and quantitative methods for the estimation of degraded endosulfan have also been elaborated. Every topic is supported with appropriate and extensive bibliography. This work should help researchers in Microbiology, Chemical analyst and professionals engaged in pesticide remediation.